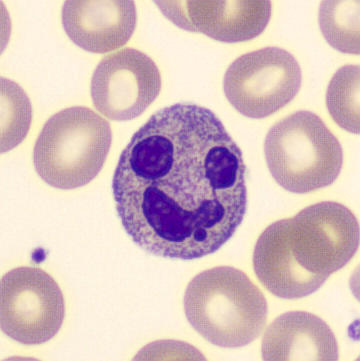
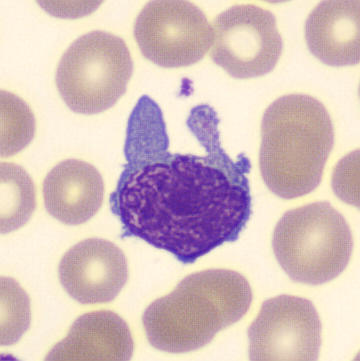

Monocytic
Nothing is more diverse than nature. Combined with external factors such as infections, malignant processes and their treatment with immunosuppressants or chemotherapy, and influenced in part by variations in collection and analysis, very unique variants of hematological cells can be sporadically observed.
The cells below have been collected over the years; many of these variants have no additional diagnostic value over the abnormalities already present in the specimen.